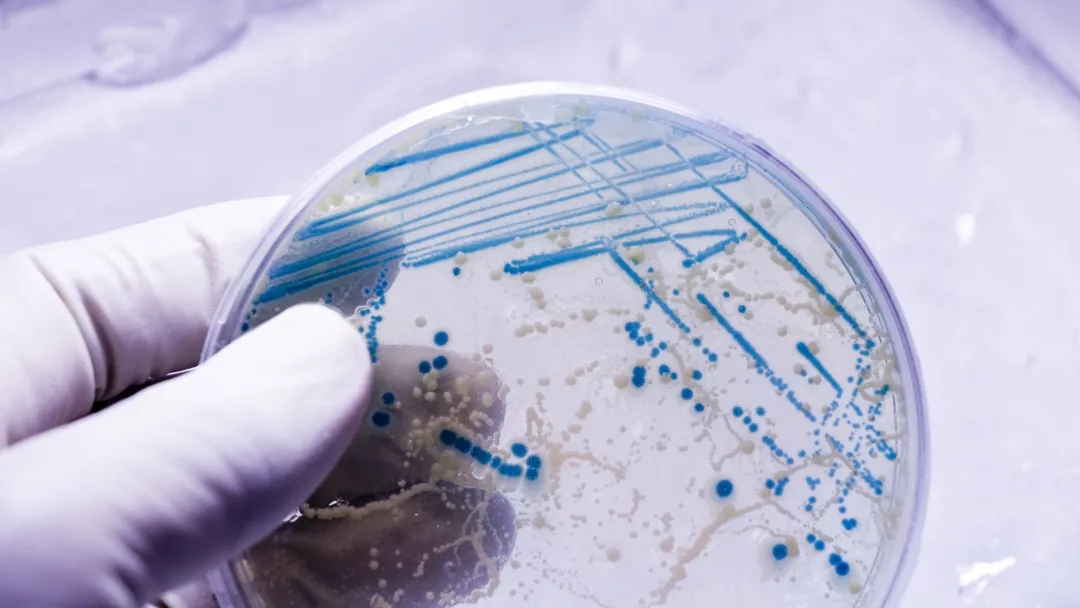

生物学专业是专注于研究细菌、动物和植物等生物体。同学们可选择系统学习该学科的整体知识体系,或深入特定专业领域。攻读生物学专业有助于学生为医疗、环境及科学领域的多种职业做好准备,也可从事科研工作,在实验室环境中开展研究。
本文将浅析选择生物学同学们常修的课程,并介绍生物学专业的不同类型。希望可以帮助大家了解生物学专业的相关内容,有助于判断生物专业是否真正适合你的未来发展路径。
小编为大家整理了常见的10个生物学课程项目,供大家参考~
普通生物学

普通生物学专业系统性地涵盖细胞结构、遗传机制、生态平衡等核心知识模块。这种宽口径的培养模式特别适合两类学生群体:一是对生命现象充满好奇但尚未明确细分方向的探索者,通过接触植物生理学、动物行为学、微生物生态学等多元领域,逐步发现自己的学术兴趣。二是有志于从事生物教育或深造的学生。
海洋生物学

海洋生物学专业以广袤的海洋为天然实验室,系统研究从潮间带到深海热泉的各类生命形态。该专业课程设置既有海洋生态学、藻类生物学等基础理论,也包含珊瑚礁保育、海洋哺乳动物行为等方向,适合对水生生物多样性充满探索热情的学生。
毕业生不仅能在水族馆、海洋公园等机构从事科普教育工作,更可参与海洋保护区规划、渔业资源管理等实践项目。
植物学

植物学专业以绿色生命体为研究对象,系统探索植物从微观生理机制到宏观生态功能的完整知识体系,既包含植物分类学、光合作用机理等基础理论,也涵盖作物育种技术、园林植物设计等应用方向。毕业生可选择的职业路径呈现多元化特征:在农业生产领域可担任作物改良技术员,在城市建设中能胜任景观设计师,教育科研方向则包括中学植物学教师等。
动物学

动物学专业以生命多样性为研究核心,系统构建从动物个体行为到种群生态的完整知识体系。本科阶段通过动物解剖学、行为生态学等基础课程建立专业框架;研究生阶段则聚焦保护生物学、动物生理学等前沿领域,为学术研究或专业实践提供深度支撑。
毕业生可选择科研方向可进入野生动物研究所开展物种保护工作,或选择实践领域在动物园担任动物保育专家或生态展区设计师。
生态与进化生物学

生态学与进化生物学专业以生命系统的动态平衡为研究对象,构建从基因适应到群落演化的完整知识框架。该专业课程设计具有鲜明的跨学科特征:基础理论模块涵盖种群生态学、生物地球化学循环等核心内容,实践应用方向则包括生态修复技术、气候变化模型等前沿领域。
毕业生可选择的职业路径呈现多元化发展态势:在公共政策领域可担任生态规划师,参与自然保护区设计;在传媒行业能胜任科学传播者,解读生物多样性保护议题;技术应用方向则包括土壤生态分析师或环境评估顾问。
微生物学

微生物学专业以微观生命系统为研究对象,构建从分子机制到群体传播的完整知识体系。该专业课程设计具有显著的交叉学科特征:核心模块涵盖病原微生物学、宿主-病原体相互作用等基础理论,延伸领域则包括生物信息学、抗生素耐药性机制等前沿课题。
毕业生可选择的职业路径呈现:科研方向可进入疾控中心开展新发传染病研究,公共政策领域则能胜任流行病学调查员或疫苗监管专员。值得关注的是,该专业与公共卫生体系高度切合,既培养学生在微生物组分析、快速检测技术等领域的实操能力,又为其应对全球健康挑战提供理论基础。
预科医学 Pre-med Studies

预科医学专业以生命科学和临床实践为双核心,构建从分子机制到人体系统的完整知识体系。该专业课程设计具有鲜明的医学导向性:基础模块涵盖人体解剖学、病理生理学等临床前学科,衔接课程则包括生物化学、医学影像原理等进阶内容,全面满足医学院入学考试(如MCAT)的知识要求。
生物医学工程

生物医学工程专业以”生命体+工程技术”为创新基点,构建从分子诊断到智能医疗的全链条知识体系。该专业课程设计具有鲜明的医工交叉特征:核心模块涵盖生物材料学、医学影像原理等基础学科,延伸领域则包括生物传感器开发、器官芯片设计等前沿技术。
毕业生可选择的职业路径呈现多元化发展态势: 在医疗设备领域可成为医学工程师或临床技术专员,在生物材料方向能胜任假肢设计师或人工器官研发工程师。
分子生物学/生物化学
分子生物学/生物化学专业以”分子-细胞-机体"为研究主线,构建从基因调控到代谢网络的系统性认知框架。该专业课程设计具有鲜明的微观导向性:核心模块涵盖蛋白质组学、信号转导通路等基础理论,延伸领域则包括基因编辑技术、生物信息学分析等前沿方法。
毕业生可选择的职业路径呈现梯度化发展特征: 产业界可进入制药企业担任医药代表或合规专员,学术界则能胜任实验室助理或科研协调员。
昆虫学

昆虫学是一门系统研究昆虫生命活动规律及其与生态环境相互作用的综合性学科。该专业通过构建从微观到宏观的知识体系,使学生全面掌握昆虫的形态结构、发育规律、遗传机制及其在生态系统中的功能角色。课程设置既包含昆虫分类学、生理生态学等基础理论,也涵盖害虫综合治理、生物防治技术等应用领域,同时注重培养学生运用现代分子生物学手段研究昆虫适应机制的能力。
毕业生可在农业植保、生物安全、生态保护等多个领域发展,既能胜任田间害虫监测与防治等实践工作,也能从事昆虫资源开发利用等创新性研究,为保障粮食安全、维护生态平衡提供专业支持。
英锐专注教育30年,升学+培训,一站式服务!
免费咨询热线:028-86619928
地址:成都市锦江区红星路三段1号IFS国际金融中心1号楼13A